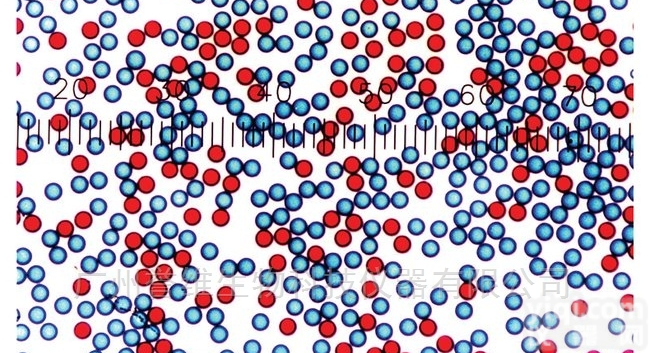
深度染色<em>羧基</em>修饰<em>微粒</em>

上海甄准生物专业代理Spherotech品Pai,原装进口,服务到位,期待您的垂询!Spherotech(SPH)公司成立于1992年,是的微球产品生产商之一, 以制造和销售生物YL和诊断应用的均一化微球为主。微球广泛应用于生物医学研究和诊断,包括免疫荧光和免疫酶学检测等。其微球适用于荧光显微镜技术、激光共聚焦(Confocal)技术、流式细胞术、影像细胞术、磁性细胞分离技术、磁珠酶免测定法(EIA)等多种检测方法。Spherotech常规生产高质量的乳胶微球、荧光微球、顺磁性微球、铁磁性微球和多种有色微球,这些微球表面可根据应用的需要添加不同的功能基团(如羧基和氨基等)。此外,Spherotech公司还生产各种包被有抗体或配体,如亲合素、链霉亲合素和生物素等的微球,用于免疫学的研究和临床。
聚苯乙烯微球的制备方法简单,单分散性好,粒径可控,聚苯乙烯与无机氧化物在物理化学性质上的差异,使得用其作为模板制备反蛋白石光子晶体时模板的去除非常容易;聚苯乙烯材料具有良好的力学性能,这使其在制备可调制光子晶体中有很好的应用,因此,聚苯乙烯(PS)微球是一类被广泛应用的制备光子晶体的材料。聚苯乙烯微球不仅具有高分子微球的一般特点,比如球形度好、比表面积大、表面反应能力、微球粒径大小均一且可控,而且还具有一些独特的性能,例如刚性大、不被一般溶剂溶解、不易生物降解等,同时聚苯乙烯微球的苯环比较活泼,可以进行一系列的功能化反应,从而赋予微球表面多种具有活性的官能团(如—OH、—COOH、—NH、—CHO等),可以更好地利用聚苯乙烯的特性。聚苯乙烯微球作为高分子功能材料,在生物医学、分析化学、有机合成、石油开采等领域中也具有十分广阔的应用前景。顺磁性物质的主要特征是,不论外加磁场是否存在,原子内部存在磁矩。但在无外加磁场时,由于顺磁物质的原子做无规则的热振动,宏观看来,没有磁性;在外加磁场作用下,每个原子磁矩比较规则地取向,物质显示极弱的磁性。磁化强度与外磁场方向一致,为正。SPH的顺磁性微球是在聚苯乙烯颗粒的表面涂覆一层氧化铁,氧化铁含量可调,一般是在10% to 15%,微球颗粒均匀,可用于细胞分离,亲和纯化,DNA探针测定等。平滑型是指在微球表面涂覆一层聚合物,以完全包封氧化铁。一是避免影响细胞内酶的活性或是与其他物质发生作用造成副作用,二是避免氧化铁的浸出。
Spherotech品Pai
平滑型羧基磁性微粒系列产品,信息如下:
| 产品编号 | 中文名称 | 英文品名 | 纯度 | 规格 |
| ZSH-CMS10-30-3 | 羧基磁性微球,平滑表面 | Carboxyl Magnetic Particles, Smooth Surface | ~1E7/mL, 3.0-3.9 um, | 3 mL |
| ZSH-CMS-80-10 | 羧基磁性微球,平滑表面 | Carboxyl Magnetic Particles, Smooth Surface | 1% w/v, 8.0-9.9 um | 10 mL |
| ZSH-CMS-200-10 | 羧基磁性微球,平滑表面 | Carboxyl Magnetic Particles, Smooth Surface | 1% w/v, 18.0-22.9 um | 10 mL |
| ZSH-CMS-30-5 | 羧基磁性微球,平滑表面 | Carboxyl Magnetic Particles, Smooth Surface | 2.5% w/v, 3.0-3.9 um, | 5 mL |
| ZSH-CMS-30-10 | 羧基磁性微球,平滑表面 | Carboxyl Magnetic Particles, Smooth Surface | 2.5% w/v, 3.0-3.9 um | 10 mL |
| ZSH-CMS-30-100 | 羧基磁性微球,平滑表面 | Carboxyl Magnetic Particles, Smooth Surface | 2.5% w/v, 3.0-3.9 um | 100 mL |
| ZSH-CMS-40-10 | 羧基磁性微球,平滑表面 | Carboxyl Magnetic Particles, Smooth Surface | 2.5% w/v, 4.0-5.0 um | 10 mL |
| ZSH-CMS-40-100 | 羧基磁性微球,平滑表面 | Carboxyl Magnetic Particles, Smooth Surface | 2.5% w/v, 4.0-5.0 um | 100 mL |
| ZSH-CMS-40-50 | 羧基磁性微球,平滑表面 | Carboxyl Magnetic Particles, Smooth Surface | 2.5% w/v, 4.0-5.0 um, | 50 mL |
更多产品请联系上海甄准生物科技有限公司
温馨提示:不可用于临床ZL。